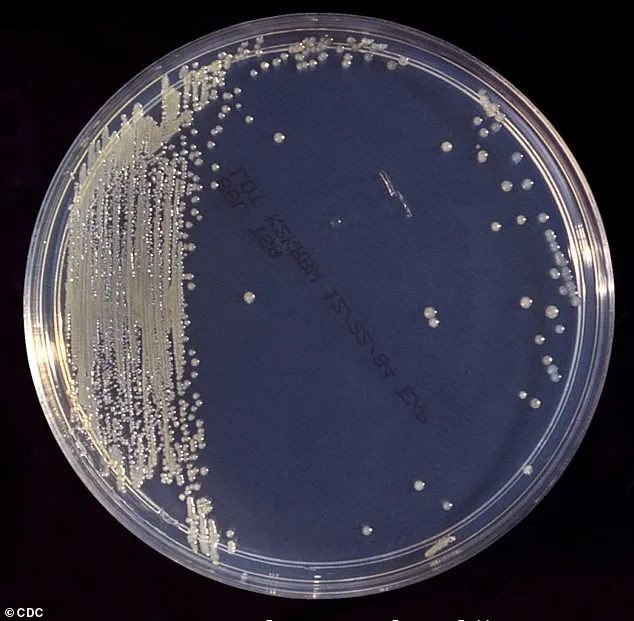
640 (7)

本周一,不幸的消息再次出现。又一名婴儿,怀疑食用雅培婴幼儿配方奶粉后,不幸离世,但是超终死亡原因仍在调查中。因此,雅培公司方面宣布,再次扩大对可能遭污染的奶粉产品的召回范围。
扩大召回奶粉批次
此次,在原有基础上,雅培公司对Similac PM 60/40婴幼儿配方奶粉进行了召回。
若罐底有#27032K80代码,或包装箱底部有#27032K800代码的奶粉,都可能遭克罗诺杆菌污染。
- Similac PM 60/40,批号为 27032K80(罐)/27032K800(箱)

雅培奶粉涉嫌受阪崎克隆杆菌感染
据报道,1月下旬,德州休斯顿一名尚未满月的男婴,在服用了雅培公司旗下Similac NeoSure 婴儿配方奶粉后,出现了呕吐和呼吸衰竭的情况。虽然医院对婴儿进行了抗生素和插管治疗,男婴超终还是因严重的肠道疾病夭折。

2月17日,FDA发布紧急公告,由于可能受克罗诺杆菌污染,提醒消费者暂时不要购买或食用雅培公司Abbott Nutrition旗下生产的的4款婴儿配方奶粉。
而在此之后,雅培也对自己在密歇根州Sturgis工厂生产的Similac®, Alimentum® ,EleCare® 3大婴儿配方奶粉进行了紧急召回。

根据FDA的消息,目前调查的5个病例中,有4人都感染了克罗诺杆菌,这是一种可以天然生活在像婴儿配方奶粉等干燥食物中的细菌。
FDA称,感染克罗诺杆菌将会危及生命或引发败血症和脑膜炎。其症状可能包括喂养不良、易怒、温度变化、皮肤或眼睛发黄、哭闹过多和动作异常。
1岁以下婴儿的初级症状通常是发烧,同时伴有喂养不良、过度哭闹或能量过低。
而且,一定程度上,感染克罗诺杆菌还会导致肠道损伤,并扩散到身体的其他部位,可能导致大脑和脊髓周围的内层肿胀。
少数婴儿还可能出现癫痫。
在2/17宣布召回的声明中,雅培表示,公司进行了“阪崎克朗杆菌和其他病原体的常规检测”。
该公司表示,在对斯特吉斯公司工厂的检测中,“发现工厂非产品接触区域存在阪崎克隆杆菌的证据”,但没有证据显示工厂存在沙门氏菌,这是第四起消费者投诉中提到的细菌。
雅培发言人Assardo 说: “没有在分销产品中检测出这两种细菌中的任何一种。”
FDA建议,使用了这些召回产品的婴儿的父母和监护人,如果担心自己孩子的健康,应该联系相关医疗机构。
此前召回奶粉批次
此次召回是在婴儿食品严重短缺的情况下进行的,影响了一些Similac、 Alimentum 和 EleCare的产品,此次召回保质期为2022年4月1日及往后日期的产品。受此次召回影响的产品在奶粉罐底部还会有一串批号数字,从头两位数字22到37开始,包含 K8、 SH 或 Z2字样的产品都在召回之列。
3大品牌奶粉编码符合如下3大情况,即为召回产品
- 批号前两位数字为:22到37

本次召回Similac、 Alimentum 和 EleCare的产品,可以通过包装底部的七到九位数字代码和有效期来识别。如果代码的前两位数字是22到37,容器上的代码包含 K8、 SH 或 Z2,并且过期日期是2022年4月1日或更晚,则产品将被包括在召回范围内。
- 外包装上的批号包含:K8、SH、Z2

- 有效期到:2022年4月1日或更晚

手把手教你如何查询召回批次
1.点击雅培召回网站,查找你所有用的配方奶粉罐的底部:找到如下图蓝色方框所示的 长串数字 Lot Number

2.如果发现 Lot Number 以字母开头,请忽略首字母,选取字母后面的7个字符填入查询框,然后点击“搜索”。
如,Lot Number 显示为 L23411SH0,那只需输入“23411SH”;Lot Number 为 31492SH0,则输入“31492SH”即可。

3.如果查询产品在召回之列
- 可以直接退回给当地零售购买处,如Costco、Walmart、CVS等
- 或者按照官网要求填写信息,并按照提示步骤办理退货,雅培公司专员会联系你退货方法

4.如有其他疑问,美国消费者还可以致电雅培客户服务 1-800-986-8540;其他国家可参考官网联系方式。
信息主要来源 NY times,NPR,Similacrecall,Dallas Morning News、Daliy Mail北美微论坛等,本文转由DM小编Wendy Gao、R,HY,Shrimy;封面来自 NBC,版权属于原作者。








































最新评论 22
: 封面这款是早产儿吃的奶粉有没有问题啊?我寄回国给我侄子吃了![[捂脸哭]](/assets/emoji/comment-emoji/dm_wulianku@2x.png?v=1)
![[捂脸哭]](/assets/emoji/comment-emoji/dm_wulianku@2x.png?v=1)
![[捂脸哭]](/assets/emoji/comment-emoji/dm_wulianku@2x.png?v=1) 封面这款是早产儿吃的奶粉有没有问题啊?我寄回国给我侄子吃了
封面这款是早产儿吃的奶粉有没有问题啊?我寄回国给我侄子吃了![[捂脸哭]](/assets/emoji/comment-emoji/dm_wulianku@2x.png?v=1)
![[捂脸哭]](/assets/emoji/comment-emoji/dm_wulianku@2x.png?v=1)
![[捂脸哭]](/assets/emoji/comment-emoji/dm_wulianku@2x.png?v=1)
: 我朋友的孩子吃了这批奶粉,出现癫痫,喂养不良…症状。好好的宝宝突然变成要靠管道进食,好心疼 我朋友的孩子吃了这批奶粉,出现癫痫,喂养不良…症状。好好的宝宝突然变成要靠管道进食,好心疼
: 水奶没有问题是吗? 水奶没有问题是吗?
: 大家不用紧张,焦虑,吃了没事就行。虽然是一批次,但是不一定每个都有。就算有,每个孩子的抗体也不一样,有的可以直接排出或是免疫系统可以直接免疫掉。人类的进化是很强大的。一共死两例,当然非常心痛,他们父母肯定无法承受,我们外人都心痛的不行,虽说是喝这个奶粉但还真不一定是奶粉的问题,美国毕竟就这两个品牌喝的奶粉,这个还占大部分。但是奶粉有感染还是很恶劣的,但愿这些商家吸取教训,以后别再出这个事了。 大家不用紧张,焦虑,吃了没事就行。虽然是一批次,但是不一定每个都有。就算有,每个孩子的抗体也不一样,有的可以直接排出或是免疫系统可以直接免疫掉。人类的进化是很强大的。一共死两例,当然非常心痛,他们父母肯定无法承受,我们外人都心痛的不行,虽说是喝这个奶粉但还真不一定是奶粉的问题,美国毕竟就这两个品牌喝的奶粉,这个还占大部分。但是奶粉有感染还是很恶劣的,但愿这些商家吸取教训,以后别再出这个事了。
: 一直显示dummy 有人有同样的情况吗? 一直显示dummy 有人有同样的情况吗?
: 天啊 我小孩已经吃了6罐 天啊 我小孩已经吃了6罐
回复 @匿名用户 : 我家的也是,怕细菌有什么长期的危害,太气人了… 我家的也是,怕细菌有什么长期的危害,太气人了…
回复 @匿名用户 : 我家的也是,不知道到底吃了多少……太可怕了 我家的也是,不知道到底吃了多少……太可怕了
: 买了寄回中国了怎么办 买了寄回中国了怎么办
: 中国雅培不管,也不可能寄回美国了,只能去官网填表格等他们联系了 中国雅培不管,也不可能寄回美国了,只能去官网填表格等他们联系了
: 都吃完了怎么办? 要看医生吗有什么症状要注意的 都吃完了怎么办? 要看医生吗有什么症状要注意的
: 同问 同问
: 昨天Target退了,网购的退gift card,店里买的就算没小票也可以退,带上当时付款的信用卡就可以~ 昨天Target退了,网购的退gift card,店里买的就算没小票也可以退,带上当时付款的信用卡就可以~
回复 @Andybaby0108 : 可以,带着会员卡去就可以,有记录的,costco都给我发email了 可以,带着会员卡去就可以,有记录的,costco都给我发email了
: costco买的,发票扔了可以退吗 costco买的,发票扔了可以退吗
: 给北美省钱快报点个赞!FDA 17号发的召回消息,Dealmoon 公众号18号早上就推送了新闻。我是看到推送,去Costco退的奶粉。感谢Dealmoon! 给北美省钱快报点个赞!FDA 17号发的召回消息,Dealmoon 公众号18号早上就推送了新闻。我是看到推送,去Costco退的奶粉。感谢Dealmoon!
回复 @Hotmamajing : 沃尔玛也不用小票,开罐了的不知道能不能,退的都是没开罐的 沃尔玛也不用小票,开罐了的不知道能不能,退的都是没开罐的
回复 @匿名用户 : Costco不用小票开罐了也可以随便退,其他商店应该要小票 Costco不用小票开罐了也可以随便退,其他商店应该要小票